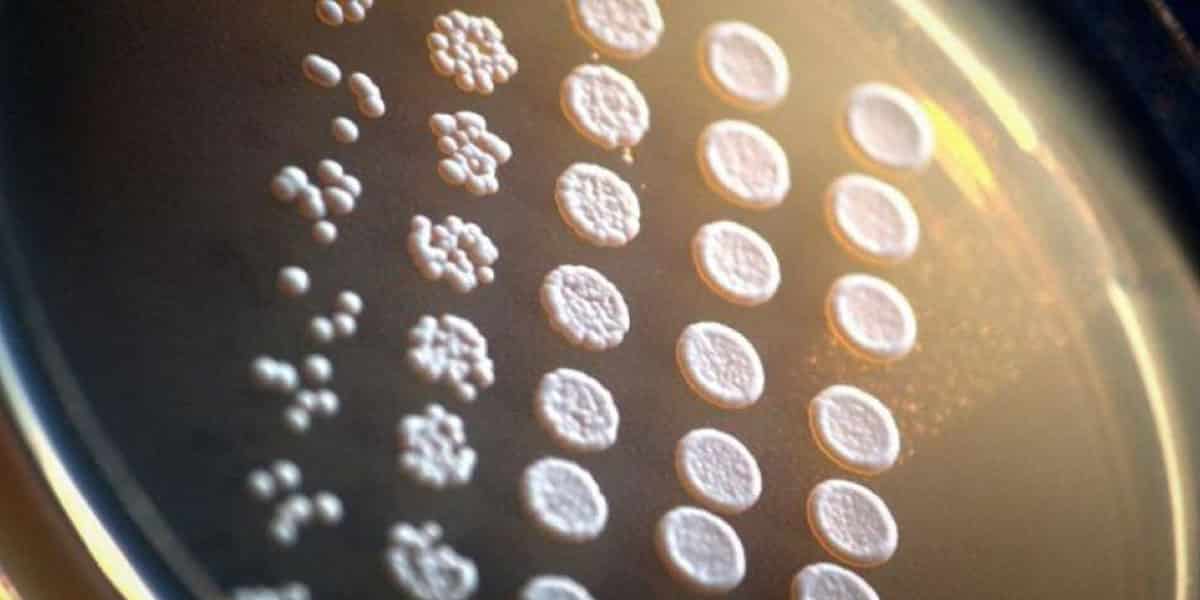
des scientifiques vont mettre au point des cannabinoïdes avec partir de la levure 1

Des scientifiques abandonnent les serres en faveur de grandes cuves en acier de levure, pour produire des cannabinoïdes comme on « brasserait » de la bière…
Produire cannabinoides — Des chercheurs mettent au point une nouvelle méthode de fabrication du tétrahydrocannabinol (THC) et du cannabidiol (CBD) à partir de cultures de levure. Deux sociétés de biotechnologie basées à San Diego, Librede et CB Therapeutics, sont en train de breveter un nouveau procédé pour isoler les cannabinoïdes sans réellement cultiver de cannabis…
Des cannabinoïdes élevés dans la levure
Bien que de nombreux patients traités au cannabis médical ne soient pas réceptifs aux approches non naturelles, certaines compagnies de l’industrie pharma voient les choses d’une tout autre façon. Northwest Arkansas Democrat-Gazette nous apprend un nouveau processus issu de la biotechnologie, les scientifiques insèrent des gènes de cannabis dans l’ADN de la levure…
Ensuite les souches mutantes de levure, produisent des molécules de THC et de CBD. Le résultat peut être récolté et commercialisé, mais ce processus nécessite d’énormes quantités de sucre. On utilise déjà la levure pour fabriquer des produits pharmaceutiques. Tout comme la Noscapine, fabriquée à partir de gènes et de levure au pavot (opium).

La noscapine est la dénomination commune internationale de la L-narcotine. C’est un alcaloïde dont les propriétés sont proches de celles de la codéine et de la morphine. On la retrouve souvent dans des sirops contre la toux.
En somme, comme les opioïdes, on peut fabriquer des cannabinoïdes de la même façon… Sher Ali Butt, cofondatrice et directrice générale de CB Therapeutics, déclare :
« Je lançais cette idée à San Diego il y a quelques années, et c’est drôle comme les choses changent. »
Des cannabinoïdes bon marché
Le cannabis et les cannabinoïdes dérivés du chanvre sont généralement cultivés naturellement, puis récoltés et extraits en laboratoire. Mais un processus moins coûteux ou moins exigeant en main-d’œuvre pourrait révolutionner l’aspect pharmaceutique du cannabis médicinal.
Intrexon, une autre société de biotechnologie synthétique du Maryland, a récemment été évaluée à une capitalisation boursière de 2,4 milliards de dollars. Intrexon, comme Librede et CB Therapeutics, annoncent qu’elles auraient mis au point une souche de levure capable de produire des cannabinoïdes. Les actions d’Intrexon ont grimpé de 27 %, rien qu’après la formulation de l’annonce.
Selon M. Butt, CB Therapeutics est prête à commercialiser son procédé en deux mois. Librede est dans une situation similaire. Avec l’approbation récente de l’Epidiolex de GW Pharmaceuticals par la Food and Drug Administration et la Drug Enforcement Administration (FDA), le potentiel commercial d’un nouveau procédé d’extraction de cannabinoïdes n’est plus à démontrer.
« Avant la légalisation en Californie, personne ne voulait prendre mon appel. J’allais quelque part, et les gens riaient de moi hors de la pièce. » Jason Poulos, fondateur de Librede
On savait déjà qu’il était possible d’extraire du CBD à partir d’une certaine race d’houblon. Mais, cette science, une fois sur le marché, serait une mine d’or pour ceux qui la perfectionneraient. En résultera, deux industries distinctes – le cannabis pharmaceutique légal – et les ingrédients stables, et bon marché dont les industries auraient besoin…
Sur le même sujet : Les cannabinoïdes et Tout savoir sur le CBD.